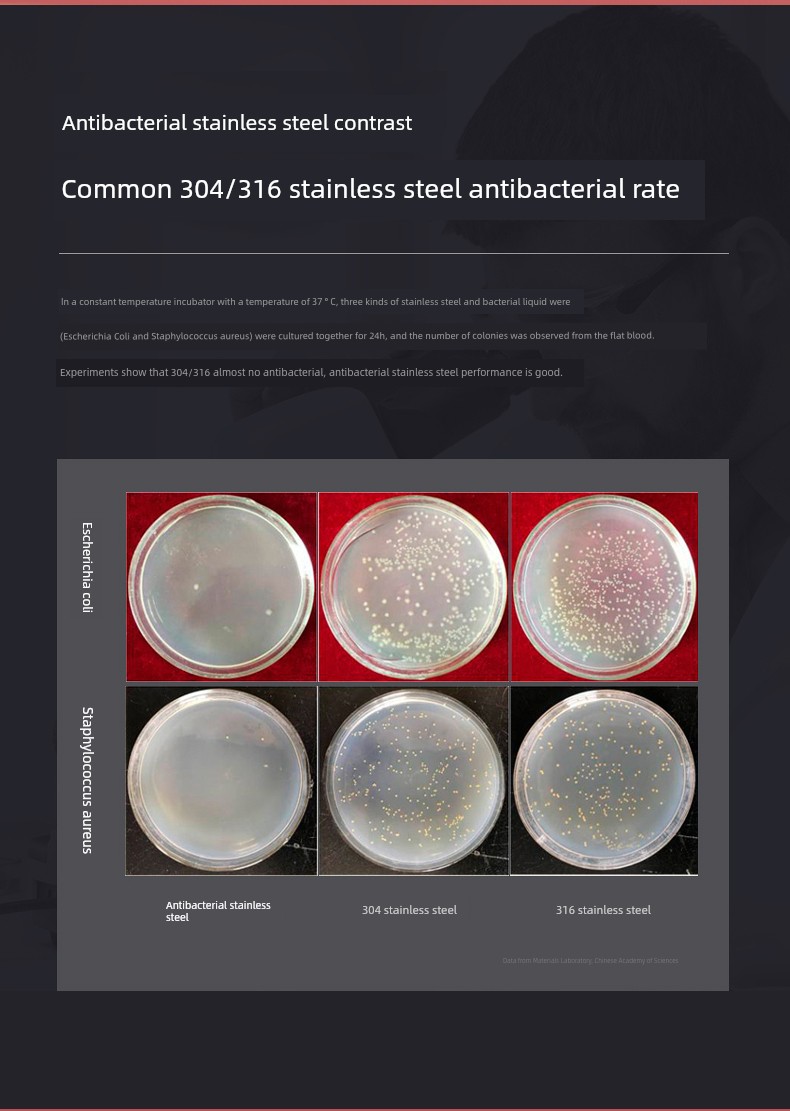

1/3




Fuguang 带吸管小学生女孩儿童保温杯
$11.26
$15.01
Fuguang 带吸管小学生女孩儿童保温杯

























No data
Fuguang 带吸管小学生女孩儿童保温杯
$ 11.26 $ 15.01
快递费用:$0.00
Fuguang 带吸管小学生女孩儿童保温杯

No data
Fuguang 带吸管小学生女孩儿童保温杯
$ 11.26 $ 15.01



